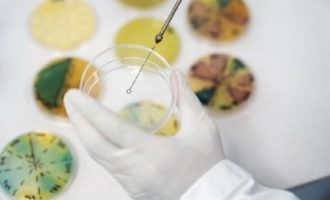

Τσίπρας σε Μητσοτάκη: Θα αναλάβεις την πολιτική ευθύνη για τις ελλείψεις σε φάρμακα ή θα συνεχίζεις να ευνοείς την αισχροκέρδεια;
Επίκαιρη ερώτηση προς τον Κυριάκο Μητσοτάκη, με θέμα «Θα αναλάβει ο Πρωθυπουργός την ελάχιστη πολιτική ευθύνη για την υγειονομική ανασφάλεια…
Περισσότερα »
ΠΡΑΣΙΝΗ ΑΡΙΣΤΕΡΑ για ελλείψεις στα φάρμακα: Υποθάλπουν κρίσεις για να κάνουν τους Μεσσίες
Οι αδιανόητες αλλά πολύ πραγματικές αντικοινωνικές πολιτικές που ακολουθεί το υπ. Υγείας, δεν διδάσκονται στα Πανεπιστήμια του εξωτερικού, αλλά στους…
Περισσότερα »
Ο Μητσοτάκης αυξάνει τις τιμές στα φάρμακα – Ο Πλεύρης άφησε τον λαό χωρίς φάρμακα
Αφού άφησαν τη χώρα χωρίς φάρμακα, οι πολιτικοί προϊστάμενοι του υπουργείου Υγείας σχεδιάζουν τώρα να αυξήσουν τις τιμές τους. Ούτε…
Περισσότερα »
Πορτοσάλτε για ελλείψεις στα φάρμακα: Να αυξηθούν οι τιμές – Στη ζωή δεν υπάρχει τσάμπα κάτι (βίντεο)
Νέες προκλητικές τοποθετήσεις έκανε ο δημοσιογράφος του ΣΚΑΪ Άρης Πορτοσάλτε με αφορμή τις ελλείψεις φαρμάκων από την ελληνική αγορά. Ο…
Περισσότερα »
Χαρίτσης για Μητσοτάκη: Αντί να απολογηθεί για ανατιμήσεις και ελλείψεις κάνει αντιπολίτευση στην αντιπολίτευση
«Αντί να απολογηθεί για τις νέες ανατιμήσεις στα τρόφιμα, τις τεράστιες ελλείψεις σε βασικά φάρμακα και το γεγονός ότι για…
Περισσότερα »
Ο Πλεύρης που άφησε τον λαό χωρίς φάρμακα τώρα λέει θα έχει γενόσημα – Ανίκανος ακροδεξιός «ψέκας»
Στο σοβαρότατο ζήτημα με τις ελλείψεις φαρμάκων που παρουσιάζονται σε όλη τη χώρα και στις παρεμβάσεις που γίνεται για να…
Περισσότερα »
Δεν υπάρχουν φάρμακα στην Ελλάδα – Το υπουργείο Υγείας του Πλεύρη άφησε τη χώρα δίχως φάρμακα
Μεγάλες ελλείψεις σε φάρμακα σε όλη τη χώρα. Μια επίσκεψη σε ένα φαρμακείο αρκεί για να αντιληφθεί κανείς το μέγεθος…
Περισσότερα »
Απελπισία από τις ελλείψεις φαρμάκων – Λείπουν πάνω από 400 βασικά φάρμακα
Απελπισία φέρνουν καθημερινά στους φαρμακοποιούς και τους ασθενείς οι ελλείψεις φαρμάκων με πάνω από 400 βασικά φάρμακα να λείπουν από…
Περισσότερα »
Ο νεοφιλελεύθερος Λίντνερ κατά της φορολόγησης των υπερκερδών εταιρειών σε καύσιμα και εμβόλια
Κατά της φορολόγησης των υπερκερδών των εταιρειών ενέργειας τάσσεται ο νεοφιλελεύθερος υπουργός Οικονομικών της κυβέρνησης Σολτς στη Γερμανία, Κρίστιαν Λίντνερ…
Περισσότερα »
ΗΠΑ: Εγκρίθηκε το φάρμακο για την ευλογιά των πιθήκων
Ο Οργανισμός Τροφίμων και Φαρμάκων των ΗΠΑ (FDA) ενέκρινε ένα νέο φάρμακο που πιστεύεται ότι θα συμβάλει στη θεραπεία της…
Περισσότερα »
Γερμανίδα Υπ. Εσωτερικών: Συγκεντρώστε σπίτια σας προμήθειες πρώτης ανάγκης και τρόφιμα
Με την παράκληση να μην υπάρξει πανικός… η Γερμανίδα υπουργός Εσωτερικών Νάνσι Φέζερ έριξε χθες «βόμβα» στην γερμανική κοινωνία, δίνοντας…
Περισσότερα »
«Θολή» τροπολογία για πλαφόν σε καύσιμα, φάρμακα, διατροφή και άλλα είδη
Πλαφόν στο μικτό περιθώριο κέρδους -και όχι στις λιανικές τιμές- σε καύσιμα, φάρμακα, διατροφή και άλλα είδη, μπαίνει μέχρι τις…
Περισσότερα »
Ξεκινά η χορήγηση αντιικών φαρμάκων – Διαδικασία και δικαιούχοι
Τα Υπουργεία Υγείας και Ψηφιακής Διακυβέρνησης ανακοινώνουν την έναρξη της διαδικασίας για την χορήγηση αντιικών φαρμάκων, της πρώτης από του…
Περισσότερα »
Μπούρλας: Έως τέλος Σεπτεμβρίου θα έχουν διανεμηθεί 20 εκατ. φάρμακα στις ΗΠΑ
Σε μια χρονική περίοδο που η Όμικρον στροβιλίζεται απειλητικά πάνω από τον πλανήτη προκαλώντας «τσουνάμι» κρουσμάτων, ο διευθύνων σύμβουλος της…
Περισσότερα »